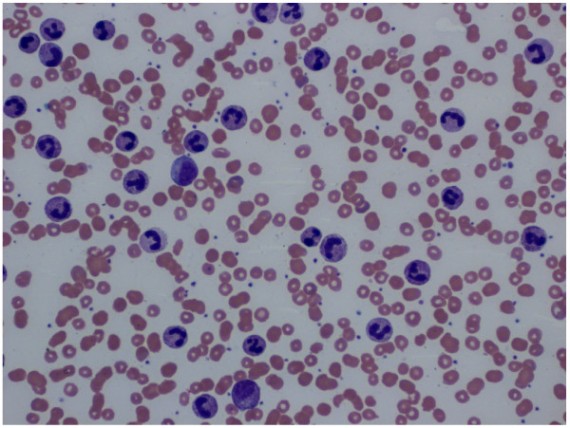
Leukocytosis

Leukocytosis, Granulocytosis, Neutrophilia
All three terms indicate increased circulating neutrophils (but not an increase in eosinophils or basophils). This is a very commonly encountered disorder in clinical medicine.
Causes: Bacterial infection; inflammation or tissue death (as in a myocardial infarction); uremia, acidosis, and other pathologic changes in the content of blood; cancer; acute hemorrhage; removal of the spleen.
Leukopenia, Neutropenia, Granulocytopenia
-penia is a suffix denoting a depression in amount. Neutropenia results from either decreased neutrophil production or abnormal destruction of neutrophils. The term usually indicates a neutrophil count below 1.50 x 103/μL.
Agranulocytosis is severe neutropenia. Neutropenia increases susceptibility to serious bacterial or fungal infection.
Causes: Decreased production of neutrophils may be due to a genetic disorder, aplastic anemia, or cancer. It is a potential adverse effect of several therapeutic agents (cancer therapy, phenothiazine, anticonvulsants, some antibiotics). Abnormal neutrophil.